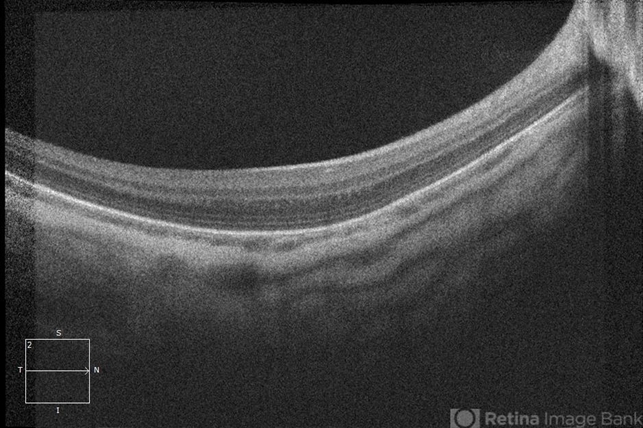
file

-
 By Guilherme Daher
By Guilherme Daher
Instituto Suel Abujamra
Co-author(s): Gabriella Mingione - Uploaded on Oct 24, 2020.
- Last modified by Caroline Bozell on Oct 29, 2020.
- Rating
- Appears in
- Oculocutaneous albinism
- Condition/keywords
- albinism, oculocutaneous albinism, optical coherence tomography (OCT), fovea, foveal hypoplasia, nystagmus
- Photographer
- Jefferson Rocha, Instituto Suel Abujamra, Sao Paulo Brazil
- Imaging device
-
Optical coherence tomography system
Zeiss Cirrus HD-OCT 5000 - Description
- Optical coherence tomography of a patient with oculocutaneous albinism showing a flat fovea.

Initializing download.
Initializing download.









